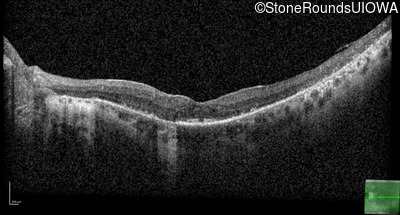

Case
SR641
Student Mode
AR Retinitis Pigmentosa (IA1aiii)
Male
Male
Hidden
SR641
Student Mode
AR Retinitis Pigmentosa (IA1aiii)
Male
Male
Highlighted Images
| Age at visit: 55 years | OD | OS |
|---|---|
History
This 55 year old myopic man first noticed reduced night vsion and some constriction of his visual field at age 21. As a young child, his best corrected visual acuity was completely normal.
| Refraction OD: | -7.75 +1.50 x 105 |
|---|---|
| Refraction OS: | -1.00 sphere (pseudophakic) |
Teaching Points
The clinical features supporting the diagnosis of MAK-associated autosomal recessive retinitis pigmentosa in this patient include: night blindness and constricted visual fields (with temporal predilection) as his earliest symptoms; bone-spicule-like pigmentation (with nasal predilection) and narrowed arterioles on fundus examination; loss of outer retinal structures on OCT; a similarly affected sibling; Jewish ethnicity; and, normally sighted parents.
| Age at visit: 48 years |
| OD | OS | ||
|---|---|---|---|
| Age at visit: 55 years |
| OD | OS | ||
|---|---|---|---|
| OD | OS | ||
|---|---|---|---|
| OD | OS | ||
|---|---|---|---|
| OD | OS | ||
|---|---|---|---|
| Age at visit: 58 years |
| Age at visit: 59 years |
| Age at visit: 63 years (Visit 2) |
| OD | OS | ||
|---|---|---|---|
| Age at visit: 66 years |
Diagnosis & molecular findings
| Disease | Gene | Allele 1 variant(s) | Allele 2 variant(s) | Inheritance mode |
|---|---|---|---|---|
| AR Retinitis Pigmentosa | MAK | Lys429 insAlu_353bp | Lys429 insAlu_353bp | AR |
Disease:
Gene:
Allele 1:
Lys429 insAlu_353bp
Allele 2:
Lys429 insAlu_353bp
Inheritance:
AR